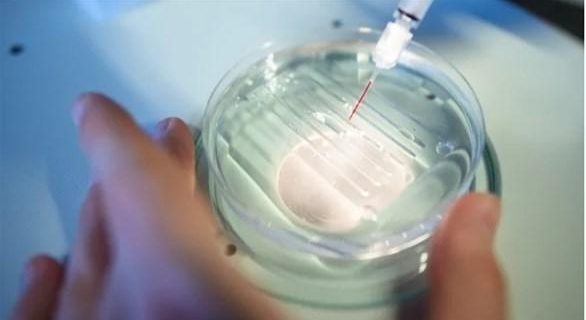

تقنية جديدة لتعديل الجينات
يَعِدُ تعديل الجينات بتقنية كريسبر بمكافحة الأمراض التي كان يُعتقد في السابق أنها غير قابلة للشفاء، لكن التقنية لا تزال تتطلب حقن المواد مباشرة في الخلايا المصابة، وهذا يجعلها غير عملية وتحتاج للتطوير.
وتشير نتائج الأبحاث إلى أن التقنية تعتمد على حقن مورث “كريسبر-كاس9 في مجرى الدم لإجراء تعديلات على الخلايا المصابة بالمرض، مما يفتح الباب على مصراعيه أمام استخدام تحرير الجينات لعلاج العديد من الأمراض الشائعة.
عالج العلاج التجريبي مرضًا وراثيًا نادرًا يدعى الداء “النشواني ترانستريتين”، حيث قام العلماء بحقن المتطوعين بجسيمات نانوية محملة بمورث كريسبر، يمكن لكبد المرضى امصتصاصها. وقاموا بتعديل جين في الكبد لتعطيل إنتاج البروتين الضار. انخفضت مستويات هذا البروتين في غضون أسابيع من الحقن، مما أدى إلى إنقاذ المرضى من مرض يمكن أن يدمر بسرعة الأعصاب والأنسجة الأخرى في أجسامهم.
شمل الاختبار ستة أشخاص فقط، ولا يزال يتعين على فريق البحث إجراء دراسات طويلة الأجل للتحقق من الآثار السلبية المحتملة. إذا ثبت أن هذه الطريقة قابلة للتطبيق على نطاق واسع، فيمكن استخدامها لعلاج أمراض مثل مرض الزهايمر وأمراض القلب، وفق ما أورد موقع “إن غادجيت” الإلكتروني.
طباعة الخبر
ارسال الخبر الى صديق



